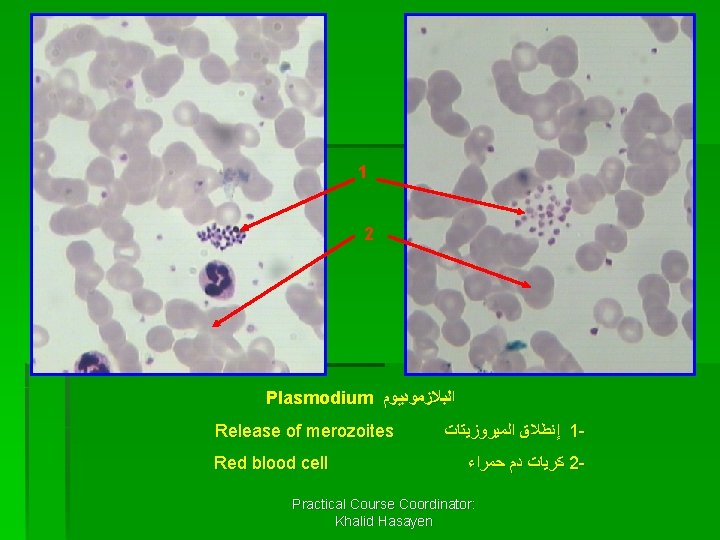
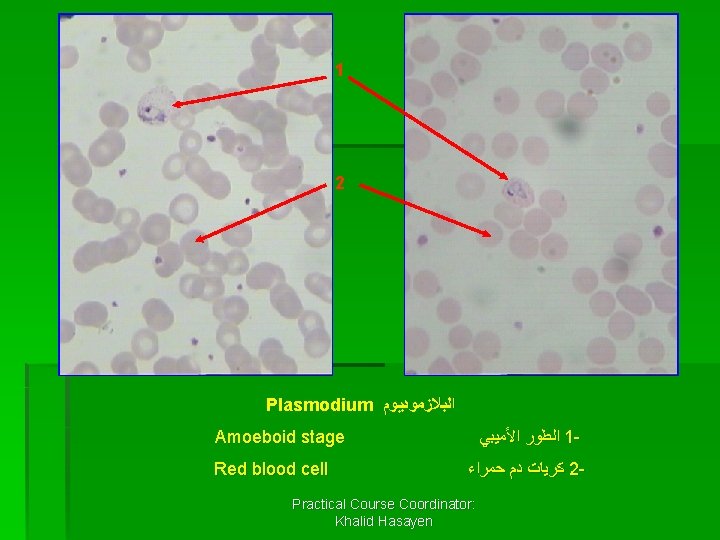

Subphylum Sarcodina Genus Amoeba Species Proteus Amoeba proteus



Subphylum: Sarcodina ﺷﻌﻴﺒﺔ ﺍﻟﻠﺤﻤﻴﺎﺕ Genus: Amoeba Species: Proteus Amoeba proteus (free living) ﺃﻤﻴﺒﺎ ﺑﺮﻭﺗﻴﻮﺱ : ﺍﻹﺳﻢ ﺍﻟﻌﻠﻤﻲ Genus: Entamoeba (sickness species) Entamoeba coli Species: histolytica Entamoeba histolytica : ﺟﻨﺲ ﺍﻻﻧﺘﺎﻣﻴﺒﺎ ﺍﻧﺘﺎﻣﻴﺒﺎ ﻛﻮﻻﻱ : ﺍﻹﺳﻢ ﺍﻟﻌﻠﻤﻲ ﺍﻧﺘﺎﻣﻴﺒﺎ ﻫﺴﺘﻮﻟﻴﺘﻴﻜﺎ : ﺍﻹﺳﻢ ﺍﻟﻌﻠﻤﻲ Practical Course Coordinator: Khalid Hasayen

Practical Course Coordinator: Khalid Hasayen

2 3 1 (Amoeba) ﺍﻷﻤﻴﺒﺎ Nucleus ﻧﻮﺍﺓ 1 - Pseudopodia ﺃﺮﺟﻞ ﻛﺎﺫﺑﺔ 2 - Food vacuole ﻓﺠﻮﺓ ﻏﺬﺍﺋﻴﺔ 3 Practical Course Coordinator: Khalid Hasayen

1 2 3 Entamoeba coli ﺣﻮﺻﻠﺔ ﺍﻧﺘﺎﻣﻴﺒﺎ ﻛﻮﻻﻱ Cyst Wall ﺟﺪﺍﺭ ﺍﻟﺤﻮﻳﺼﻠﺔ 1 - 4 -8 Nuclei ( ﺃﻨﻮﻳﺔ 2 - (4 -8 Cytoplasm ﺳﻴﺘﻮﺑﻼﺯﻡ 3 - Practical Course Coordinator: Khalid Hasayen

1 2 3 Entamoeba histolytica ﺣﻮﺻﻠﺔ ﺍﻧﺘﺎﻣﻴﺒﺎ ﻫﺴﺘﻮﻟﻴﺘﻜﺎ Cyst Wall ﺟﺪﺍﺭ ﺍﻟﺤﻮﻳﺼﻠﺔ 1 - 1 -4 Nuclei ( ﺃﻨﻮﻳﺔ 2 - (1 -4 Cytoplasm ﺳﻴﺘﻮﺑﻼﺯﻡ 3 - Practical Course Coordinator: Khalid Hasayen

Subphylum: Mastigophora ﺷﻌﻴﺒﺔ ﺍﻟﺴﻮﻃﻴﺎﺕ Class: Phytomastigophora ﻃﺎﺋﻔﺔ ﺍﻟﺴﻮﻃﻴﺎﺕ ﺍﻟﻨﺒﺎﺗﻴﺔ Genus: Euglena viridis Practical Course Coordinator: Khalid Hasayen ﺟﻨﺲ ﺍﻟﻴﻮﺟﻠﻴﻨﺎ

Practical Course Coordinator: Khalid Hasayen

1 3 2 (Euglena) ﺍﻟﻴﻮﺟﻠﻴﻨﺎ Flagellum ﺍﻟﺴﻮﻁ 1 - Contractile vacuole Nucleus ﻓﺠﻮﺓ ﻣﺘﻘﺒﻀﺔ 2 - Practical Course Coordinator: Khalid Hasayen ﻧﻮﺍﺓ 3 -

Subphylum: Mastigophora ﺷﻌﻴﺒﺔ ﺍﻟﺴﻮﻃﻴﺎﺕ Class: Zoomastigophora ﻃﺎﺋﻔﺔ ﺍﻟﺴﻮﻃﻴﺎﺕ ﺍﻟﺤﻴﻮﺍﻧﻴﺔ Genus: Trypanosoma ﺟﻨﺲ ﺍﻟﺘﺮﻳﺒﺎﻧﻮﺳﻮﻣﺎ Species: gambiense Trypanosoma gambiense ﺗﺮﻳﺒﺎﻧﻮﺳﻮﻣﺎ ﺟﺎﻣﺒﻴﺎﻧﺴﻲ : ﺍﻹﺳﻢ ﺍﻟﻌﻠﻤﻲ Practical Course Coordinator: Khalid Hasayen

Practical Course Coordinator: Khalid Hasayen

1 2 3 4 (Trypanosoma) ﺍﻟﺘﺮﻳﺒﺎﻧﻮﺳﻮﻣﺎ Red blood cell ﻛﺮﻳﺎﺕ ﺩﻡ ﺣﻤﺮﺍﺀ 1 - Flagellum ﺍﻟﺴﻮﻁ 2 - Undulating membrane Nucleus ﻏﺸﺎﺀ ﻣﺘﻤﻮﺝ 3 - Practical Course Coordinator: Khalid Hasayen ﻧﻮﺍﺓ 4 -

Phylum: Ciliophora ﺷﻌـﺒﺔ ﺍﻟﻬﺪﺑﻴﺎﺕ Genus: Paramecium ﺟﻨﺲ ﺑﺮﺍﻣﻴﺴﻴﻮﻡ Practical Course Coordinator: Khalid Hasayen

Practical Course Coordinator: Khalid Hasayen

1 4 2 3 4 (Paramecium) ﺍﻟﺒﺮﺍﻣﻴﺴﻴﻮﻡ Cilia ﺃﻬﺪﺍﺏ 1 - macronucleus ﻧﻮﺍﺓ ﻛﺒﻴﺮﺓ 2 - micronucleus ﻧﻮﺍﺓ ﺻﻐﻴﺮﺓ 3 - Contractile vacuole ﻓﺠﻮﺓ ﻣﺘﻘﺒﻀﺔ 4 - Practical Course Coordinator: Khalid Hasayen

Class: Sporozoa ﻃﺎﺋﻔﺔ ﺍﻟﺒﻮﻏﻴﺎﺕ Genus: Plasmodium malariae ﺟﻨﺲ ﺑﻼﺯﻣﻮﺩﻳﻮﻡ ﻣﻼﺭﻳﺎ : ﺍﻹﺳﻢ ﺍﻟﻌﻠﻤﻲ Practical Course Coordinator: Khalid Hasayen


1 2 Plasmodium ﺍﻟﺒﻼﺯﻣﻮﺩﻳﻮﻡ Schizonte(formation of merozoites) ( ﺍﻟﺸﻴﺰﻭﻧﺖ) ﺗﻜﻮﻳﻦ ﺍﻟﻤﻴﺮﻭﺯﻳﺘﺎﺕ 1 - Red blood cell Practical Course Coordinator: Khalid Hasayen ﻛﺮﻳﺎﺕ ﺩﻡ ﺣﻤﺮﺍﺀ 2 -
1 2 Plasmodium ﺍﻟﺒﻼﺯﻣﻮﺩﻳﻮﻡ Release of merozoites Red blood cell ﺇﻧﻄﻼﻕ ﺍﻟﻤﻴﺮﻭﺯﻳﺘﺎﺕ 1 ﻛﺮﻳﺎﺕ ﺩﻡ ﺣﻤﺮﺍﺀ 2 - Practical Course Coordinator: Khalid Hasayen

1 2 Plasmodium ﺍﻟﺒﻼﺯﻣﻮﺩﻳﻮﻡ Ring Stage Red blood cell ﺍﻟﻄﻮﺭ ﺍﻟﺤﻠﻘﻲ 1 ﻛﺮﻳﺎﺕ ﺩﻡ ﺣﻤﺮﺍﺀ 2 - Practical Course Coordinator: Khalid Hasayen

Ring Stage ﺍﻟﻄﻮﺭ ﺍﻟﺤﻠﻘﻲ Practical Course Coordinator: Khalid Hasayen
1 2 Plasmodium ﺍﻟﺒﻼﺯﻣﻮﺩﻳﻮﻡ Amoeboid stage Red blood cell ﺍﻟﻄﻮﺭ ﺍﻷﻤﻴﺒﻲ 1 ﻛﺮﻳﺎﺕ ﺩﻡ ﺣﻤﺮﺍﺀ 2 - Practical Course Coordinator: Khalid Hasayen

Plasmodium ﺍﻟﺒﻼﺯﻣﻮﺩﻳﻮﻡ Gametocyte ﺍﻟﻄﻮﺭ ﺍﻟﺠﺎﻣﻴﺘﻲ Practical Course Coordinator: Khalid Hasayen
- Slides: 24